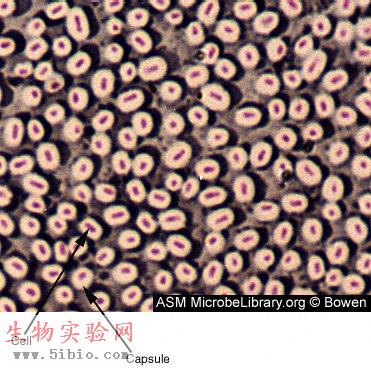

|
原核细胞(prokaryotic cell)没有核膜,遗传物质集中在一个没有明确界限的低电子密度区(图3-5),称为拟核(nucleoid)。DNA为*的环状分子,通常没有结合蛋白,环的直径约为2.5nm,周长约几十纳米。大多数原核生物没有恒定的内膜系统,核糖体为70S型,原核细胞构成的生物称为原核生物,均为单细胞生物。

图3-5 大肠杆菌TEM照片,核区为低电子密度区
一、细菌
细菌是在自然界分布最广、个体数量最多的有机体,是大自然物质循环的主要参与者。细菌主要由细胞壁、细胞膜、细胞质、核质体等部分构成,有的细菌还有夹膜、鞭毛、菌毛等特殊结构(图3-6)。绝大多数细菌的直径大小在0.5~5μm之间。可根据形状分为三类,即:球菌(图3-7)、杆菌(图3-8)和螺旋菌(包括弧形菌,图3-9)。

图3-6细菌的结构,图片来自http://www.rkm.com.au
?

图3-7淋病球菌图片来自http://www.denniskunkel.com/

图3-8 大肠杆菌图片来自http://www.denniskunkel.com/

图3-9 弧形霍乱菌图片来自http://www.denniskunkel.com/
(一)细胞壁
细胞壁厚度因细菌不同而异,一般为15-30nm。主要成分是肽聚糖,由N-乙酰葡糖胺和N-乙酰胞壁酸构成双糖单元,以β(1-4)糖苷键连接成大分子。N-乙酰胞壁酸分子上有四肽侧链,相邻聚糖纤维之间的短肽通过肽桥(革兰氏阳性菌)或肽键(革兰氏阴性菌)桥接起来(图3-10),形成了肽聚糖片层,像胶合板一样,粘合成多层。
肽聚糖中的多糖链在各物种中都一样,而横向短肽链却有种间差异。革兰氏阳性菌细胞壁厚约20~80nm,有15-50层肽聚糖片层,每层厚1nm,含20-40%的磷壁酸(teichoic acid)[2],有的还具有少量蛋白质。革兰氏阴性菌细胞壁厚约10nm,仅2-3层肽聚糖,其他成分较为复杂,由外向内依次为脂多糖、细菌外膜和脂蛋白。此外,外膜与细胞之间还有间隙。
肽聚糖是革兰阳性菌细胞壁的主要成分,凡能破坏肽聚糖结构或抑制其合成的物质,都有抑菌或杀菌作用。如溶菌酶是N-乙酰胞壁酸酶,青霉素抑制转肽酶的活性,抑制肽桥形成。

图3-10 细胞壁的结构
细菌细胞壁的功能包括:保持细胞外形;抑制机械和渗透损伤(革兰氏阳性菌的细胞壁能耐受20kg/cm2的压力);介导细胞间相互作用(侵入宿主);防止大分子入侵;协助细胞运动和分裂。
脱壁的细胞称为细菌原生质体(bacterial protoplast)或球状体(spheroplast,因脱壁不完全),脱壁后的细菌原生质体,生存和活动能力大大降低。
(二)细胞膜
是典型的单位膜结构,厚约8~10nm,外侧紧贴细胞壁,某些革兰氏阴性菌还具有细胞外膜。通常不形成内膜系统,除核糖体外,没有其它类似真核细胞的细胞器,呼吸和光合作用的电子传递链位于细胞膜上。某些行光合作用的原核生物(蓝细菌和紫细菌),质膜内褶形成结合有色素的内膜,与捕光反应有关。某些革兰氏阳性细菌质膜内褶形成小管状结构,称为中膜体(mesosome)或间体(图3-11),中膜体扩大了细胞膜的表面积,提高了代谢效率,有拟线粒体(Chondroid)之称,此外还可能与DNA的复制有关。

图3-11 白喉杆菌的间体
(三)细胞质与核质体
细菌和其它原核生物一样,没有核膜,DNA集中在细胞质中的低电子密度区,称核区或核质体(nuclear body)。细菌一般具有1-4个核质体,多的可达20余个。核质体是环状的双链DNA分子,所含的遗传信息量可编码2000~3000种蛋白质,空间构建十分精简,没有内含子。由于没有核膜,因此DNA的复制、RNA的转录与蛋白的质合成可同时进行,而不像真核细胞那样这些生化反应在时间和空间上是严格分隔开来的。
每个细菌细胞约含5000~50000个核糖体,部分附着在细胞膜内侧,大部分游离于细胞质中。细菌核糖体的沉降系数为70S,由大亚单位(50S)与小亚单位(30S)组成,大亚单位含有23SrRNA,5SrRNA与30多种蛋白质,小亚单位含有16SrRNA与20多种蛋白质。30S的小亚单位对四环素与链霉素很敏感,50S的大亚单位对红霉素与氯霉素很敏感。
细菌核区DNA以外的,可进行自主复制的遗传因子,称为质粒(plasmid)。质粒是*的环状双链DNA分子,所含遗传信息量为2~200个基因,能进行自我复制,有时能整合到核DNA中去。质粒DNA在遗传工程研究中很重要,常用作基因重组与基因转移的载体。
胞质颗粒是细胞质中的颗粒,起暂时贮存营养物质的作用,包括多糖、脂类、多磷酸盐等。
(四)其他结构
许多细菌的最外表还覆盖着一层多糖类物质,边界明显的称为荚膜(capsule,图3-12),如肺炎球菌,边界不明显的称为粘液层(slime layer),如葡萄球菌。荚膜对细菌的生存具有重要意义,细菌不仅可利用荚膜抵御不良环境;保护自身不受白细胞吞噬;而且能有选择地粘附到特定细胞的表面上,表现出对靶细胞的专一攻击能力。例如,伤寒沙门杆菌能专一性地侵犯肠道淋巴组织。细菌荚膜的纤丝还能把细菌分泌的消化酶贮存起来,以备攻击靶细胞之用。
图3-12 一种细菌的负染照片,显示荚膜 图片来自http://www.microbelibrary.org
鞭毛(图3-13)是某些细菌的运动器官,由一种称为鞭毛蛋白(flagellin)的弹性蛋白构成,结构上不同于真核生物的鞭毛。细菌可以通过调整鞭毛旋转的方向(顺和逆时针)来改变运动状态。
菌毛(图3-14)是菌体表面极其的蛋白纤细,须用电镜观察。特点是:细、短、直、硬、多,菌毛与细菌运动无关,根据形态、结构和功能,可分为普通菌毛和性菌毛两类。前者与细菌吸附和侵染宿主有关,后者为中空管子,与传递遗传物质有关。

图3-13 细菌的鞭毛 图片来自http://www.denniskunkel.com/
?

图3-14 大肠杆菌的菌毛图片来自http://www.denniskunkel.com/
(五)繁殖
细菌一二分裂的方式繁殖(图3-15),某些细菌处于不利的环境,或耗尽营养时,形成内生孢子,又称芽孢(图3-16),是对不良环境有强抵抗力的休眠体,由于芽胞在细菌细胞内形成,故常称为内生孢子。

图3-15 大肠杆菌的分裂 图片来自http://www.denniskunkel.com/
芽孢的生命力非常顽强,有些湖底沉积土中的芽抱杆茵经500-1000年后仍有活力,肉毒梭菌的芽孢在pH 7.0时能耐受100℃煮沸5-9.5小时。芽孢由内及外有以下几部分组成:
1.芽孢原生质(spore protoplast,核心core):含浓缩的原生质。
2.内膜(inner membrane):由原来繁殖型细菌的细胞膜形成,包围芽孢原生质。
3.芽孢壁(spore wall):由繁殖型细菌的肽聚糖组成,包围内膜。发芽后成为细菌的细胞壁。
4.皮质(cortex):是芽孢包膜中最厚的一层,由肽聚糖组成,但结构不同于细胞壁的肽聚糖,交联少,多糖支架中为胞壁酐而不是胞壁酸,四肽侧链由L-Ala组成。
5.外膜(outer membrane):也是由细菌细胞膜形成的。
6.外壳(coat):芽孢壳,质地坚韧致密,由类角蛋白组成(keratinlike protein),含有大量二硫键,具疏水性特征。
7.外壁(exosporium):芽孢外衣,是芽孢的最外层,由脂蛋白及碳水化合物(糖类)组成,结构疏松。
?

图3-16 Bacillus anthracis的芽孢(B) 图片来自http://www.microbelibrary.org
二、支原体
支原体(mycoplasma)的大小通常为0.2~0.3μm,可通过滤菌器。无细胞壁,不能维持固定的形态而呈现多形性(图3-17)。细胞膜中胆固醇含量较多,约占36%,这对保持细胞膜的完整性是必需的,凡能作用于胆固醇的物质(如二性霉素B、皂素等)均可引起支原体膜的破坏而使支原体死亡。

图3-17 肺炎支原体 图片来自http://s99.middlebury.edu/BI330A/
支原体基因组为一环状双链DNA,分子量小(仅有大肠杆菌的五分之一),合成与代谢很有限。肺炎支原体的一端有一种特殊的末端结构(terminal structure),能使支原体粘附于呼吸道粘膜上皮细胞表面,与致病性有关。
三、衣原体和立克次氏体
衣原体(Chlamydia)很小,直径200nm-500nm,能通过细菌滤膜。立克次氏体(Rickettsia)略大,大多不能通过滤菌膜。它们都有DNA和RNA,有革兰氏阴性细菌特征的含肽聚糖的细胞壁,但酶系统不完全,必须在寄主细胞内生活,有摄能寄生物(energe parasite)之称。
砂眼是衣原体引起的,由于能形成包含体,起初被认为是大型病毒,1956年,我国著名微生物学家汤飞凡及其助手张晓楼等人首次分离到沙眼的病原体。
衣原体生活史特殊,具有感染力的个体称为原体(elementory body),体积小,有坚韧的细胞壁(图3-18)。在宿主细胞内,原体逐渐伸长,形成无感染力的个体,称作始体(initial body),是一种薄壁的球状细胞,体积较大,通过二等分裂的方式在宿主细胞内形成一个微菌落,随后大量的子细胞有分化为具有感染能力的原体。

图3-18 衣原体Chlamydia pneumoniae 梨子形的原体(EBs),左、吸附在巨噬细胞表面,右、进入细胞内部的原体,图片来自iwww.bioscience.org/2002/ v7/e/hahn/figures.htm
立克次氏体(图3-19)也是专性细胞内寄生的,主要寄生于节肢动物,有的会通过蚤、虱、蜱、螨传入人体、如斑疹伤寒、战壕热。美国医生H.T.Richetts 1909年首次发现它是落基山斑疹伤寒的病原体,并于1910年牺牲于此病,故后人称这类病原体为立克次氏体。与衣原体的不同处在于其细胞较大,无滤过性,合成能力较强,且不形成包涵体。

图3-19 附着在内皮细胞表面的立克次氏体和细胞内包含立克次氏体的内吞体 图片来自http://www.microbelibrary.org
四、蓝藻
蓝藻(图3-20)又称蓝细菌(cyanobacterium),能进行与高等植物类似的光合作用(以水为电子供体,放出O2),与光合细菌的光合作用的机制不一样,因此被认为是最简单的植物。蓝藻没有叶绿体,仅有十分简单的光合作用结构装置。蓝藻细胞遗传信息载体与其它原核细胞一样,是一个环状DNA分子,但遗传信息量很大,可与高等植物相比。蓝藻细胞的体积比其它原核细胞大得多,直径一般在士10um,甚至可达70μm(颤藻)。蓝藻属单细胞生物,有些蓝藻经常以丝状的细胞群体存在,如:属蓝藻门念珠藻类的发菜(nostoc commune var.flagtlliforme)就是蓝藻的丝状体;做绿肥的红萍实际上是一种固氮蓝藻与水生蕨类满江红的共生体。

图3-20 项圈藻Anabaena Cyanobacteria 图片来自 http://www.microbelibrary.org
五、古细菌(archaebacteria)
是一类很持殊的细菌,多生活在极端的生态环境中。具有原核生物的某些特征,如无核膜及内膜系统;也有真核生物的特征,如以甲硫氨酸起始蛋白质的合成、核糖体对氯霉素不敏感、RNA聚合酶和真核细胞的相似、DNA具有内含子并结合组蛋白;此外还具有既不同于原核细胞也不同于真核细胞的特征,如:细胞膜中的脂类是不可皂化的;细胞壁不含肽聚糖,有的以蛋白质为主,有的含杂多糖,有的类似于肽聚糖,但都不含胞壁酸、D型氨基酸和二氨基庚二酸。
极端嗜热菌(themophiles):能生长在90℃以上的高温环境。如斯坦福大学科学家发现的古细菌,最适生长温度为100℃,80℃以下即失活,德国的斯梯特(K. Stetter)研究组在意大利海底发现的一族古细菌,能生活在110℃以上高温中,最适生长温度为98℃,降至84℃即停止生长;美国的J. A. Baross发现一些从火山口中分离出的细菌可以生活在250℃的环境中。嗜热菌的营养范围很广,多为异养菌,其中许多能将硫氧化以取得能量。
极端嗜盐菌(extremehalophiles):生活在高盐度环境中,盐度可达25%,如死海和盐湖中。
极端嗜酸菌(acidophiles):能生活在pH值1以下的环境中,往往也是嗜高温菌,生活在火山地区的酸性热水中,能氧化硫,硫酸作为代谢产物排出体外。
极端嗜碱菌(alkaliphiles):多数生活在盐碱湖或碱湖、碱池中,生活环境pH值可达11.5以上,最适pH值8~10。
产甲烷菌(metnanogens):是严格厌氧的生物,能利用CO2使H2氧化,生成甲烷,同时释放能量。
CO2+4H2→CH4+2H2O+能量
由于古细菌所栖息的环境和地球发生的早期有相似之处,如:高温、缺氧,而且由于古细菌在结构和代谢上的特殊性,它们可能代表最古老的细菌。它们保持了古老的形态,很早就和其它细菌分手了。所以人们提出将古细菌从原核生物中分出,成为与原核生物(即真细菌eubacteria)、真核生物并列的一类。
表3-2 原核细胞与真核细胞的区别
区别
原核细胞
真核细胞
大小
1~10μm
10~100μm
细胞核
无核膜
有双层的核膜
染色体
形状
环状DNA分子
线性DNA分子
数目
一个基因连锁群
2个以上基因连锁群
组成
DNA*或结合少量蛋白质
DNA同组蛋白和非组蛋白结合
DNA序列
无或很少有重复序列
有重复序列
基因表达
RNA和蛋白质在同一区间合成
RNA在核中合成和加工;蛋白质在细胞质中合成
细胞分裂
二分或出芽
有丝分裂和减数分裂,少数出芽生殖。
内膜
无独立的内膜
有,分化成各种细胞器
鞭毛构成
鞭毛蛋白
微管蛋白
光合与呼
吸酶分布
质膜
线粒体和叶绿体
核糖体
70S(50S+30S)
80S(60S+40S)
营养方式
吸收,有的行光合作用
吸收,光合作用,内吞
细胞壁
肽聚糖、蛋白质、脂多糖、脂蛋白
纤维素(植物细胞)
六、细胞结构与生物系统
传统分类法根据生物的营养方式、运动能力和细胞结构的特点,把生物划分为动物界和植物界。植物细胞的主要特征是具有硬的细胞壁和进行光合作用的叶绿体。按传统分类系统,虽然大多数生物种容易归类,可是对某些生物来说却遇到了分类上的困难,例如眼虫(Euglena)是一种单细胞生物,含有叶绿体,却不具有细胞壁;细菌和真菌则有细胞壁而无叶绿体;支原体既无叶绿体也无细胞壁,古细菌既有原核生物的特征也具有真核生物的特征。这些生物按照传统分类法进行分类显然就要遇到困难。
1970年C. Woese根据对16SrRNA核苷酸顺序的同源性比较,提出将生命划分为三界,即:真细菌(Eubacteria)、真核生物Eucaryotes、古细菌(Archaes)。1996年Bult领导的研究小组在Science上发表了詹氏甲烷球菌(Methanococcus jannaschii)的全基因组序列,进一步证明它既不是典型的细菌也不是典型的真核生物,而是介于两者之间的生命体,即生命的第三形式。
表3-3 几种分类系统
传统分类
按细胞结构分类
细胞类型
Whittaker 1969
Dodson 1971
植物界
细菌
蓝藻
原核生物界
细菌
蓝细菌
原核生物界
细菌
蓝细菌
原核细胞
金藻
绿藻
红藻
褐藻
粘菌
真正真菌
苔藓维管植物
原生动物
后生动物
维管植物
原生生物界
金藻
原生动物
植物界
金藻
绿藻
红藻
褐藻
粘菌
真正真菌
苔藓
维管植物
真核细胞
真菌界
粘菌
真正真菌
绿藻
红藻
褐藻
苔藓
维管植物
动物界
原生动物
后生动物
动物界
后生动物
动物界
原生动物
后生动物
|